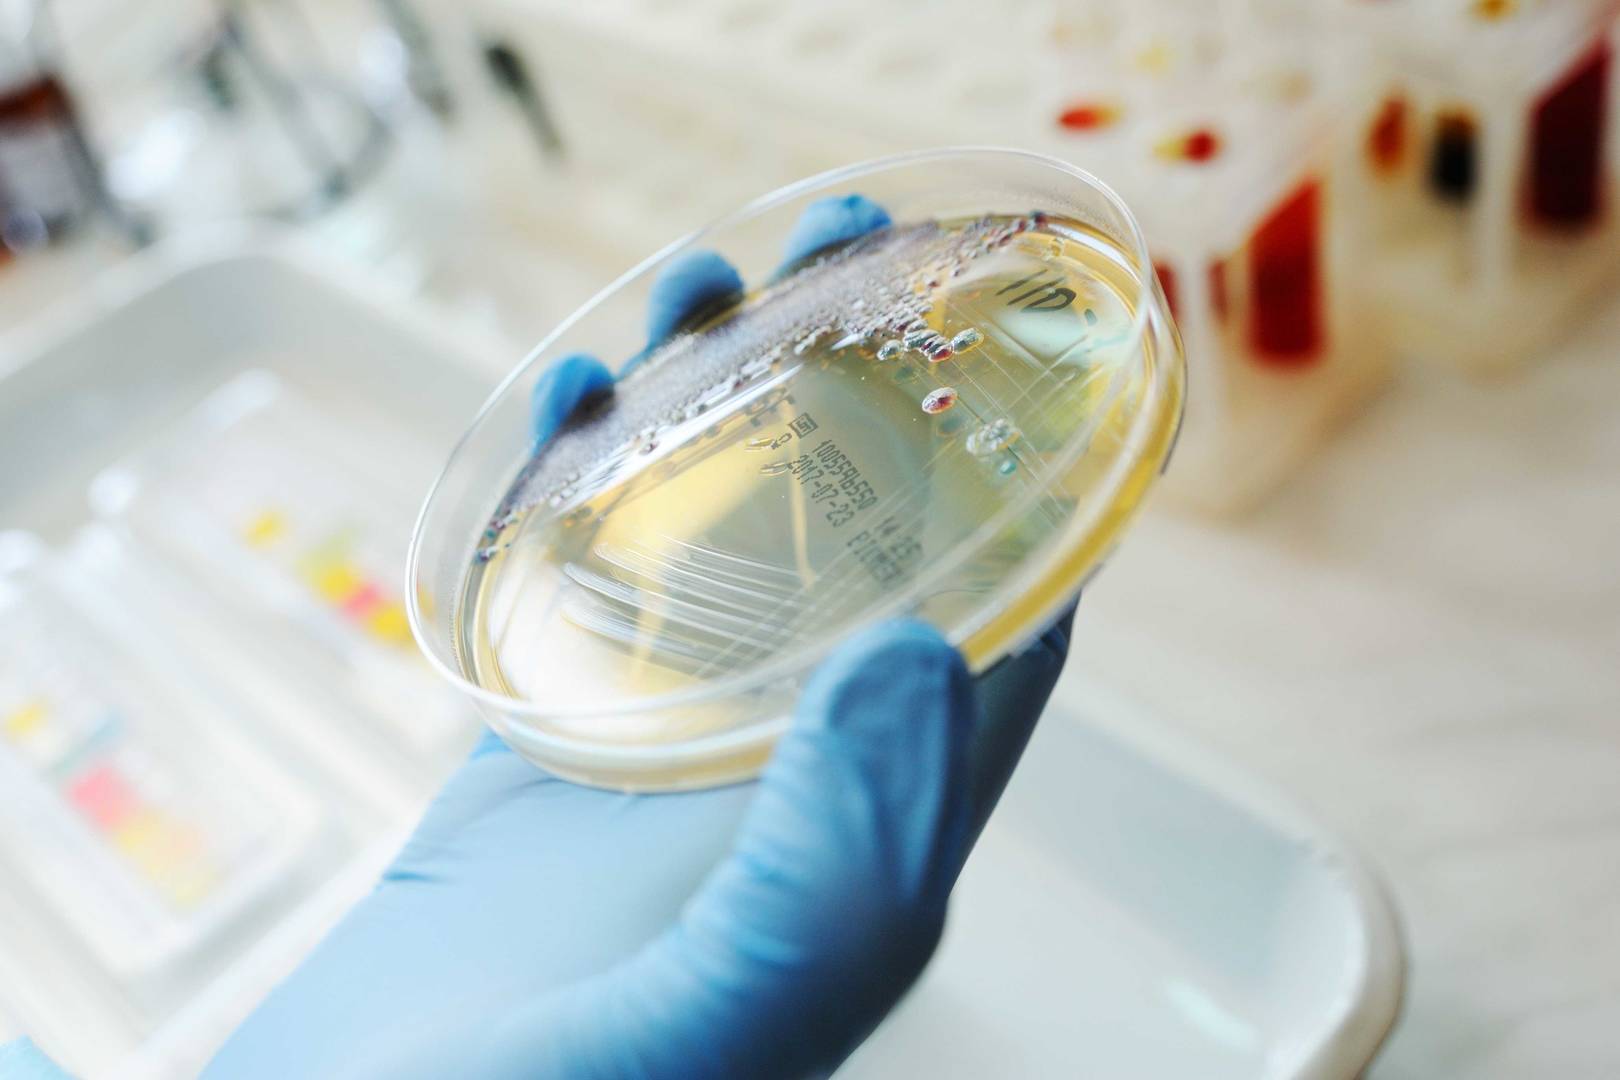
Petriskål i hånd

Våre akkrediterte analysetjenester for næringsmidler bidrar til å sikre at produktene dine oppfyller myndighetskrav og forbrukernes forventninger.
Fra mikrobiologi og hygienemonitorering til næringsinnholdsanalyse og påvisning av allergener, og toksiner tilbyr vi presise og pålitelige analyser på tvers av alle sentrale områder innen mattrygghet og kvalitet.
Samarbeid med oss for å beskytte merkevaren din og gi kundene dine trygghet.